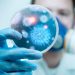
No todo es COVID-19:  los otros virus que están en circulación

Regionales 10 de mayo de 1933
“La declaración del estado de guerra entre Paraguay y Bolivia es consecuencia directa del fracaso de las gestiones pacifistas”, de esta forma La Mañana titulaba la noticia de la vuelta al conflicto en el centro de América del Sur.
Luego del estancamiento de las negociaciones llevadas adelante por los países limítrofes (Argentina, Brasil, Chile y Perú) que lograron un cese al fuego parcial a la guerra iniciada en setiembre de 1932, el gobierno de Paraguay declara la guerra a Bolivia en base a que esta pretendía demorar las propuestas diplomáticas para obtener una mejor posición a la hora de negociar. Este conflicto, que duró tres años, fue el más importante de América del Sur en el siglo XX y tuvo una gran cantidad de bajas para ambos bandos (60.000 de las 250.000 tropas que Bolivia movilizó y Paraguay perdió 30.000 de los 120.000 soldados). La región del Gran Chaco tenía una importancia estratégica para Bolivia debido a que anteriormente había perdido su salida al mar en la Guerra del Pacífico (1879-1883) y mediante el río Pilcomayo o Río Paraguay, tendría una salida hacia el mar (Océano Atlántico). Además el Chaco estaba en su mayoría despoblado y cuando ambos países se independizaron heredaron de la época colonial una casi inexistente delimitación que solo comenzó a ser necesaria cuando la región tomó mayor importancia económica con la aparición de petróleo. Este petróleo lo extraía la empresa estadounidense, Standard Oil, en la zona boliviana. Además, el Chaco solo tenía utilidad económica en las cercanías al río Paraguay con la explotación del quebracho colorado para la producción de taninos (compuesto para curtir pieles) y para hacer postes o durmientes para el ferrocarril. La situación de la región donde se libraron los combates era crítica, con un clima tropical de sabana más al este y más árido al oeste, el Chaco tenía temperaturas que podían llegar a los 50 grados en verano y a menos de 0 durante el invierno. Sumado al calor extenuante, la mayoría de las fuentes de agua eran saladas y las pocas que eran potables tuvieron una gran importancia durante la guerra aunque su contaminación generó grandes bajas en ambos bandos por disentería.
La estrategia boliviana se apoyó en la indudable superioridad de recursos económicos y de población (2 a 1) que tenía sobre Paraguay y le sirvió para mantener la delantera durante el primer tramo de la guerra. Pero a nivel táctico aún utilizaban las teorías de cargas frontales masivas de los inicios de la Primera Guerra Mundial, algo que causaba grandes cantidades de bajas y que estaba en desuso a nivel de las doctrinas militares más avanzadas. Paraguay, por su lado, evitaba el choque frontal y buscaba hacer los “corralitos”, es decir cerco y aniquilamiento de las tropas enemigas, buscando priorizar el movimiento para cortar los suministros bolivianos. A nivel del ejército, Paraguay tenía homogeneidad entre la tropa y sus superiores ya que todos tenían las mismas costumbres y hablaban naturalmente sus dos idiomas: el guaraní y el español. El ejército boliviano estaba compuesto por distintos grupos étnicos y existían amplias diferencias de clase social entre soldados y oficiales, siendo un ejemplo que los aimaras que fueron reclutados no sabían hablar español. También, a nivel de la moral, se recibió con gran entusiasmo en la capital paraguaya, Asunción, la noticia de la declaración de guerra que recién había terminado de firmar el presidente de la República y que el parlamento había aprobado por unanimidad. Bordenave, el ministro de gobierno, afirmó que “era el único camino que quedaba para salvar el honor del país”. A su vez, todos los niveles de la sociedad paraguaya se unieron nuevamente detrás del gobierno y el ejército como había ocurrido 60 años antes en la Guerra de la Triple Alianza, en lo que fue una guerra total. Se colaboró con todo tipo de acciones, desde la nación como a nivel internacional, aumentando la producción para que el país tuviera mayores divisas y obtuviera capital para destinarlo a la defensa del país. En el caso de Bolivia, existían diferencias políticas entre el Estado Mayor boliviano y el presidente, Daniel Salamanca, que facilitaron que hubiera hasta cuatro generales dirigiendo a las fuerzas bolivianas durante un conflicto que tuvo menos de tres años de duración. En cambio, Paraguay tuvo a José Félix Estigarribia como comandante en jefe durante todo el conflicto y el presidente, Eusebio Ayala, complementó en sus funciones políticas y económicas para que el país tuviera un liderazgo efectivo y que el 12 de junio de 1935 terminaran los combates, logrando Paraguay reconquistar la mayoría del Chaco (que tiene un tamaño de 650.000 kilómetros cuadrados, mayor extensión que España o Alemania). En 1938 se firmaría el Tratado de Paz, Amistad y Límites, en el que Paraguay queda con tres partes de la región y Bolivia ocupa la zona restante.
Quien no fue ajeno al conflicto en el centro de nuestro continente fue Luis Alberto de Herrera, el caudillo blanco siempre apegado a las causas americanistas. Al saber del inicio de la guerra, se pone a las órdenes del gobierno paraguayo y llega el 16 de septiembre de 1932 a Asunción. En su libro “Herrera, Caudillo Oriental”, el escritor y legislador Eduardo Víctor Haedo describe cómo fue recibido por el pueblo paraguayo: “El recibimiento a Herrera, resultó una inmensa fiesta nacional. Diez mil personas fueron a recibirle. Con las escuelas públicas, la juventud universitaria, altos funcionarios, damas y niñas, el ministro uruguayo, personalidades del clero y el ejército, representantes del presidente de la república y varios ministros. Desde una tribuna de la plazoleta del puerto, saludóle el suscrito, a nombre del pueblo paraguayo, diciéndole que en su persona se concretaba el Uruguay de hoy de ayer, y que no podría darse representante más típico del país, abundando en grandes elogios”. El afecto de Paraguay hacia Herrera tiene base en sus libros: “La diplomacia oriental en el Paraguay I y II” (1908 y 1911 respectivamente), en los cuales reafirma la gesta del mariscal Solano López frente a la injusta y brutal guerra de la Triple Alianza (1864-1870), que sumió al Paraguay en la miseria y destrucción. Luego del gran recibimiento por el pueblo hermano de Paraguay, Herrera se presentó en el despacho del ministro de Defensa, Victor Rojas, y solicitó ser conducido al Chaco, en donde participó de la Batalla de Boquerón. Ya en el campo de batalla, por su austeridad y simpleza, se gana el aprecio de la tropa paraguaya y estos le llaman el “Doctor soldado”, haciéndose popular en las trincheras. Según las crónicas del momento estuvo solamente “con el mismo traje gris con que salió de Asunción (el único que ha llevado al frente), traje que empieza a añorar ya las suavidades de un planchado, con la camisa mostrando las huellas de la tierra y del barro con el mismo aspecto que presentan nuestros soldados, así el Dr. Herrera, tres veces candidato a la presidencia del Uruguay, cumple con honor de soldado en el ejército paraguayo”. Por esto mismo, hoy una importante calle de la capital de ese país lleva el nombre Luis Alberto de Herrera, como así también un barrio.
Atentado contra el Papa Juan Pablo II
Internacionales
13 de marzo de 1981
“¡Se salva! El Papa fuera de peligro, tras dos balazos que hirieron al mundo”. De esta manera La Mañana titulaba en su portada la noticia sobre el intento de asesinato que sufrió el sumo pontífice. En la Plaza de San Pedro, durante una multitudinaria procesión, un joven turco llamado Mehmet Ali Agca, perteneciente al grupo terrorista “Lobos Grises”, efectuó cuatro disparos que impactaron tanto en el estómago como en ambas manos de Juan Pablo II. El joven extremista había previamente escrito una carta dirigida a un diario de Estambul en donde amenazaba de muerte al sumo pontífice. Recuperados de la sorpresa que les produjo el incalificable atentado, efectivos de seguridad, de la policía italiana y de la Guardia Suiza lograron rescatar vivo al extremista de una multitud que quería lincharlo. Luego del atentado, Juan Pablo II fue llevado con rapidez a un hospital, donde fue sometido a transfusiones de sangre y operado con éxito. Este atentado fue el primero contra el máximo líder de la iglesia desde que Pablo VI fuera apuñalado por un artista boliviano en 1970 cuando llegó al aeropuerto de Manila para visitar Filipinas.
TE PUEDE INTERESAR